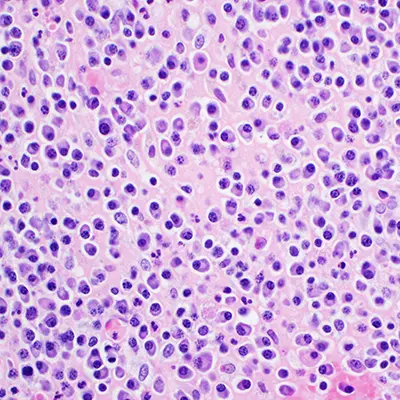
Mieloma Múltiple

Hematología y Oncología
en la Ciudad de México y Tlaxcala
La hematología es la especialidad que se dedica al tratamiento de los pacientes con enfermedades de la sangre. Su campo de actuación es el diagnóstico, tratamiento, estudio e investigación de la sangre y los órganos hematopoyéticos (médula ósea, ganglios linfáticos y bazo) tanto sanos como enfermos.
Enfermedades
Tratamientos
Procedimientos
CDMX: 555 511 5601